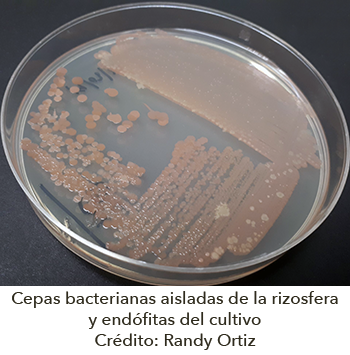

Biofertilizantes para una agricultura sustentable
Randy Ortiz Castro
Red de Estudios Moleculares Avanzados

El cultivo de maíz en México representa uno de los granos de gran importancia en la base alimentaria y de biodiversidad en México. El uso de herramientas biotecnológicas y sustentables como la formulación de biofertilizantes con bacterias promotoras del crecimiento vegetal representan una estrategia frente a la alta demanda del cultivo frente al aumento de la población. El desarrollo de biofertilizantes de aislados bacterianos asociados a cultivos nativos de maíz favorecerán una mayor ventaja en la producción del cultivo reduciendo los costos de producción y amigables con el ambiente.
El constante crecimiento de la población mundial demanda un aumento en la producción de granos y semillas como fuente de alimentación. Se estima una población mundial para el año 2050 la población alcanzará un total de 9 mil 700 millones de personas en la Tierra, por lo que incrementar la producción de granos y semillas es de vital importancia.


Parcela del cultivo de maíz criollo y cepas bacterianas aisladas de la rizosfera y endófitas del cultivo. Crédito: Randy Ortiz-Castro
En México, el cultivo del maíz es considerado como uno de los granos importantes como base de la alimentación desde los diferentes usos en los pueblos rurales hasta la base de alimentación para la producción de proteína, además de ser un componente fundamental del patrimonio gastronómico, cultural y de identidad de los mexicanos. Se cuenta con una superficie de 8.5 millones de hectáreas, cuenta con un mayor número de variedades nativas, actualmente se tienen registradas 59 razas nativas mexicanas únicas, y es centro de origen de la biodiversidad del maíz. Desde 1980 México ha duplicado su producción anual de maíz. En México se consumen 45 millones de toneladas de grano de maíz en todo el país, de los cuales 8 millones son destinados para consumo humano, 3.5 son de maíz amarillo y 4.5 de maíz blanco. Recientemente, México se enfrenta a una necesidad de importar granos debido aun mayor demanda de consumo que de producción, importando el 40% de los 45 millones de toneladas.


Ilustración de la planta de Arabidopsis thaliana e interacción con bacterias en cultivo en condiciones de laboratorio. Crédito: Randy Ortiz-Castro
Sin embargo, el incremento de la producción dependerá de diferentes estrategias biotecnológicas y sustentables frente al uso desmedido de herbicidas y fertilizantes que afectan el medio ambiente. Una de las estrategias biotecnológicas es la identificación y caracterización de variedades de maíz tolerantes a diferentes condiciones ambientales como sequía, salinidad y disponibilidad de nutrientes. El Centro Internacional de Mejoramiento de Maíz y Trigo (CIMMYT) tiene como objetivo en conjunto con diferentes órganos de gobierno, centros de investigación nacional e internacional, organizaciones de productores y sector privado, aumentar la productividad y rentabilidad del maíz de una manera sustentable preservando la riqueza genética y diversidad del maíz.

 Otro de los factores principales en el incremento de la producción del maíz cuyo reto a nivel nacional es alcanzar una producción de 3.5 toneladas por hectárea, por lo que en regiones con una baja producción dependen del implemento de mejores estrategias del uso de variedades altamente productivas y aprovechamiento óptimo de fertilizantes.
Otro de los factores principales en el incremento de la producción del maíz cuyo reto a nivel nacional es alcanzar una producción de 3.5 toneladas por hectárea, por lo que en regiones con una baja producción dependen del implemento de mejores estrategias del uso de variedades altamente productivas y aprovechamiento óptimo de fertilizantes.
Recientemente el uso de microorganismos, bacterias u hongos, han representado una estrategia biotecnológica sustentable en la reducción del uso de fertilizantes químicos. El desarrollo de bio-fertilizantes a base de microorganismos como bacterias promotoras del crecimiento vegetal representan una estrategia sustentable reduciendo costos de producción hasta en un 50% del uso de fertilizantes.
Recientemente el uso de microorganismos, bacterias u hongos, han representado una estrategia biotecnológica sustentable en la reducción del uso de fertilizantes químicos. El desarrollo de bio-fertilizantes a base de microorganismos como bacterias promotoras del crecimiento vegetal representan una estrategia sustentable reduciendo costos de producción hasta en un 50% del uso de fertilizantes.
En un estudio reciente en el Laboratorio de Microbiología Ambiental se aislaron y caracterizaron bacterias asociadas a cultivos de maíz criollo tanto, bacterias que viven en la rizosfera, porción de suelo que rodea a la raíz, o bacterias endófitas que inducen el crecimiento vegetal de las plantas. Estas bacterias con capacidad en la promoción del crecimiento vegetal o por sus siglas en inglés como PGPR, han sido descritas como promotoras por su capacidad de favorecer el crecimiento vegetal a través de diferentes efectos en la planta ya sea que favorecen la disponibilidad de los nutrientes del suelo como fosfatos y nitrógeno, o bien, producen compuestos tipo hormonas vegetales como las auxinas que favorecen el crecimiento y producción de las plantas (Figura 1).
Una de las estrategias en la evaluación de cultivos bacterianos es el uso de plantas modelo de estudio como Arabidopsis thaliana, que permiten una rápida evaluación y en condiciones de laboratorio para poder controlar las condiciones de crecimiento, como la luz, temperatura y humedad, reduciendo tiempos de evaluación y formulación de biofertilizantes que posteriores pruebas a nivel de invernadero y de campo podrían ser utilizados para incrementar la producción de los cultivos de importancia agrícola como el maíz y sorgo (Figura 2).
En nuestro estudio se identificaron aislados bacterianos con capacidad en la promoción del crecimiento vegetal a través de la producción de compuestos del tipo auxinas, como se pudo observar en las líneas de Arabidopsis que permiten visualizar la producción de auxinas en la planta (Figura 3).
Es imperante que el uso de estrategias biotecnológicas y sustentables con el ambiente, que en conjunto con productores, sector gubernamental e instituciones de investigación, impactarán en la productividad agrícola y seguridad alimentaria en México.
Referencias
- La importancia del maíz y su impacto en la economía y la cultura mundial . https://thefoodtech.com/seguridad-alimentaria/la-importancia-del-maiz-y-su-impacto-en-la-economia-y-la-cultura-mundial/
- Los desafíos a los que se enfrenta el maíz en México. https://thefoodtech.com/seguridad-alimentaria/los-retos-a-los-que-se-enfrenta-el-maiz-en-mexico/
- Maíz para México. Plan Estratégico 2030. Centro Internacional de Mejoramiento de Maíz y Trigo (CIMMYT).
- Zaida Asunción Hernández Martínez (2019) Aislamiento y caracterización de bacterias con actividad promotora del crecimiento vegetal asociadas al maíz criollo de una región del Estado de Guerrero. Tesis de Licenciatura.
"La opinión es responsabilidad de los autores y no representa una postura institucional"
